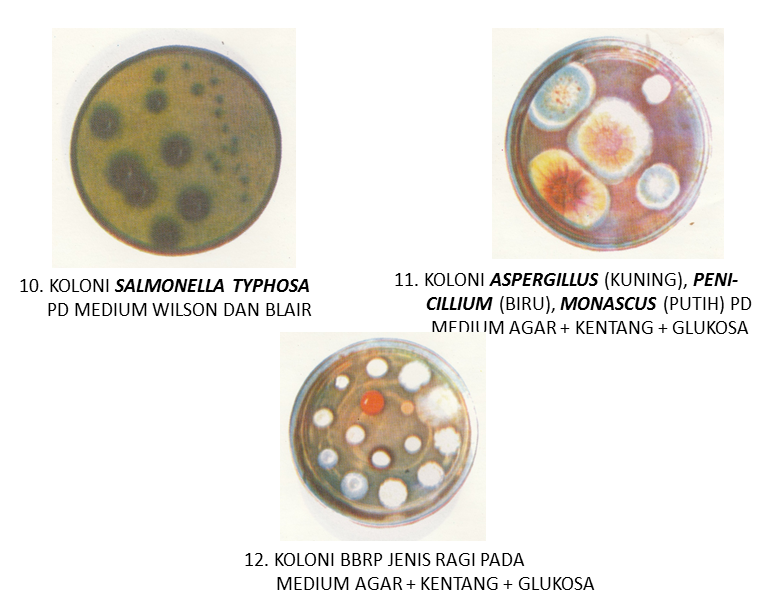

Pendahuluan
• Bakteri
dapat diperoleh dari mana-mana,
– Dari
rongga mulut bahkan
dpt ditemukan dari;
– Dari
sela-sela gigi air
sumur/minum, dan makanan
– Dari
tanah banyak sampah
– Sisa-sisa
makanan yg sudah basi
• Biasanya
kita awali dengan biakan di dalam cawan
petri (petri dish) yang berisi zat makanan atau medium.
• Dengan
membiarkan medium dalam cawan petri terbuka sela-ma ± 24 jam, akan kita dapati
berpuluh-puluh koloni bakteri dan jamur (cendawan) menutup permukaan medium
tersebut.
• Rebusan
kentang yang sudah dikuliti, maupun jenang dodol, dapat digunakan sebagai
medium sederhana
• Koloni
cendawan segera dpt dibedakan dari koloni bakteri; kolo ni cendawan
memperlihatkan benang-benang miselium. Koloni bakteri nampak seperti sekelumit
mentega, air susu atau percik-an sari buah yang kental, spt ada tetes minyak
diatas air.
• Untuk
mengetahui sifat morfologi bakteri, maka dapat diperiksa di dalam keadaan hidup
atau mati.
• Pemeriksaan
morfologi diperlukan untuk mengenali
nama bak teri→ identifikasi
• Diperlukan
juga pengenalan sifat-sifat fisiologinya, bahkan sifat-sifat fisiologi
kebanyakan merupakan faktor penentu dlm
mengenali nama spesies atau bakteri.
Pemeriksaan bakteri
dalam keadaan hidup
• Pemeriksaan
bakteri hidup harus dikerjakan dengan hati-hati, lebih-lebih jika yang akan
diperiksa bakteri patogen
• Untuk
mengetahui tingkah laku bakteri, biasanya dilakukan pengamat-an bakteri pada
tetes bergantung (“hunger droping”), dengan memper-gunakan peralatan:
• Selembar
gelas penutup (cover glass) yang bersih
• Selembar
gelas benda (gelas obyek) bercekungan ditengah-tengahnya
• Kawat
inokulasi (jarum ose) kawat lurus panjang ± 10 cm, ѳ < 0,5 mm, bergagang
kayu satu ujung dan ujung lain-nya dilengkung melingkar
• Kawat
inokulasi untuk memindahkan mikro organisme dari satu tem-pat ke tempat yang
lain. Sebaiknya dibuat dari kawat yang tidak mudah berkarat dan tidak terlalu
lemas
• Mikroskop
cahaya
• Lampu
bunsen berisi spiritus, yang dinyalakan. Dengan api untuk mem-buat ujung ose membara setiap kali
akan dipakai memindahkan bakteri. Sebelum, dan sesudah digunakan harus disterilkan
• Satu
tindakan untuk mesterilkan jarum ose tersebut
• Enkass;
tempat inokulasi suci hama sederhana
Gambar 1.a kaca
penutup dengan setetes suspensi bakteri. B. Ialah a dalam posisi
Terbalik diatas
cekungan gelas obyek c d. Sediaan yang siap diperiksa (diamati) de
Ngan mikroskop,e.
Lampu bunsen, f. Jarum ose (jarum inokulasi), g. Tabung berisi
Biakan bakteri.
(dwidjoseputro, 1998, dasar-dasar mikrobiologi, gbr 1, hal 13)
Gambar enkas, dengan dinding dibuat dari fiberglass
Gambar laminar air flow
Pemeriksaan bakteri
dalam keadaan hidup
• Keuntungan
penggunaan metode hunger-drop adalah:
• Bakteri
berada terkurung di dalam cekungan gelas
obyek, se-hingga bahaya kemungkinan tersebarnya ke lingkungan sekitar hampir
tidak ada
• Bakteri
dpt bergerak leluasa, jika yg diamati adalah bakteri yg suka bergerak. Tidak
semua spesies bakteri dpt bergerak
• Cara
lain untuk mengamati bakteri hidup adalah dengan tetes-an medium yang tidak
menggantung. Caranya lebih mudah, ti-dak diperlukan gelas obyek yang bercekungan
di tengah, cukup dengan gelas obyek datar biasa.
• Kawat
inokulasi (jarum ose) yg telah membawa bakteri, disen-tuhkan atau dioleskan
ditengah-tengah gelas obyek kemudian ditutup dengan gelas penutup, sebagai
sediaan yg siap dipe-riksa. Sediaan seperti ini kurang aman, dan tidak
memberikan kebebasan gerak bakteri
Pemeriksaan bakteri
dalam keadaan mati
• Sediakan
sebuah gelas obyek yang bersih (diseka dengan alkohol 70%).
• Ambil
sedikit sampel bakteri yg dipiara dalam medium cair , atau dari suatu koloni yg
terdapat pada medium padat.
• Pengambilan
dengan jarum ose seperti yg telah disebutkan sebelum-nya. Apuskan ujung jarum
ose yg telah membawa bakteri di tengah-2 gelas obyek bersih, sehingga terjadi
suatu pembidangan seluas ± 1 cm2. Jika jarum ose diposisikan agak
sejajar dengan permukaan gelas benda penggesekan dapat lebih mudah dan lebih
merata, sehingga bakteri tidak dlm posisi bertimbun pada suatu tempat tertentiu
• Bila
sampel (contoh) bakteri diambil dari koloni pada medium padat, sebelum
diapuskan, permukaan gelas obyek tersebut dilumuri air dulu sebelum jarum ose
dioleskan/diapuskan. Tdk ada air dipermukaan gelas obyek bila sampel bakteri
diambil dr piaraan dlm medium air.
• Tunggu
sampai apusan agak mengering diudara, kemudian gelas obyek lewatkan diatas nyala
api, perlahan-lahan sampai apus menjadi kering. Usahakan agar supaya apus
bakteri tidak kena api langsung, jadi yg dikenakan api adalah bidang dataran
gelas obyek yg tidak di apus
Pemeriksaan bakteri
dalam keadaan mati
• Jika
apusan bakteri sudah kering benar, dapat dimulai prosedur pewarnaan bakteri
• Ada
banyak sekali metode pewarnaan bakteri, tetapi yang lazim dipakai hanya sekitar
12 metode saja
• Bakteri
hidup tidak tampak jelas bentuk maupun sifat-sifat morfologik lainnya
• Bakteri
tunggal, yaitu yg hanya berupa satu sel saja, nampak hanya be-ning, walau
bakteri tersebut berasal dari koloni yg mempunyai warna tertentu
• Untuk
memperlihatkan inti atau bahan-bahan , ada pewarnaan sendiri, untuk flagel ada
cara lain, demikian pula pewarnaan untuk memperli-hatkan spora
• Cara
mewarnai, diusulkan oleh para cerdik pandai, sehingga metode pewarnaan sering
disebut menurut nama sarjana yg menemukan; misal pewarna inti disebut pewarna
feulgen. Pewarna giemsa, pewarna gram, pewarna neisser, dan lain-lain
• Pewarna
yg digunakan , biru methilin, merah safranin, dsb. Zat pewar-na yang digunakan
bisa bersifat asam, netral atau basa.
Petunjuk umum untuk
mewarnai bakteri
• Bakteri
harus diambil dari suatu biakan yg masih muda, ± umur 24 jam; sebagai usia yg
baik untuk memperlihatkan bentuk mor-fologinya. Jika diinginkan melihat bakteri
membentuk spora, diperlukan bakteri yg lebih tua, yaitu dari biakan berumur 2
s.d. 3 kali 24 jam.
• Bakteri
diratakan di atas gelas obyek yang benar-benar bersih, seluas sekitar 1 cm2.
Hindari pengambilan bakteri terlalu ba-nyak, karena akan menyebabkan terjadinya
penumpukan yang akan menyulitkan pada pengamatan bentuknya. Harus dibuat apus
tipis, sehingga dapat diperoleh sediaan satu per satu bak-teri, yang dapat
memperlihatkan bentuk bakteri tersebut.
• Jika
apus sudah kering, sediaan perlu dilewatkan di atas nyala api perlahan-lahan,
agar bakteri benar-benar melekat pada ge-las obyek, dengan demikian tidak akan
terhapus bila sediaan dicuci. Jaga agar bidang yang mengandung bakteri tidak
kena nyala api.
• Zat
pewarna, yg dalam bentuk larutan, diteteskan pada bidang yang mengandung
bakteri. Atau gelas obyek direndam seluruh-nya miring pada larutan zat pewarna,
tergantung pada sifat khusus zat pewarna, dan kadang-kadang bergantung pada
ba-nyak sedikitnya gelas obyek (sediaan) yang harus dibuat. Diberi waktu
beberapa lama agar diserap oleh bakteri yg sudah kering tersebut, yg bergantung
pada sifat khas zat pewarna yg diguna-kan
• Selanjutnya
sediaan dicuci dengan alkohol atau asam encer, untuk menghilangkan zat warna
yang berlebihan. Alkohol yg digunakan untuk mencuci dapat berupa larutan 15%
hingga 90% kadang-kadang diperlukan juga alkohol 100% (alkhol absolut). Caranya
mencuci, cukup dengan mencelupkansediaan ke dalam alkohol atau ke dalam asam
encer dengan tidak usah diusap ataupun digesek. Ada pula zat pewarna yng cukup
dicuci dengan air murni atau air biasa dari kran.
• Sediaan
ditunggu kering lagi, temperatur kamar.jika sudah ke-ring, sediaan dapat
diperiksa dengan mikroskop, bila perlu dng menggunakan minyak cedar (oli imersi
atau minyak celup). Jika dikehendaki, sediaan dapat ditutup dengan gelas
penutup (co-ver glass) sebelum ditempatkan di atas meja mikroskop.
• Sediaan
yg diinginkan untuk disimpan lama, perlu perlakuan sebagai berikut:
• Permukaan
yg mengadung bakteri ditetesi balsem kanada, ke-mudian ditutup dengan gelas
penutup yg bersih, dengan catat-an sebelum balsem kanada kering betul, sediaan jangan dile-takkan
miring dan sesudah balsem kanada betul-2 kering, sedi-aan dapat disimpan dalam
kotak penyimpanan dlm posisi miring
• Selanjutnya
sediaan (preparat) disimpan dalam gelap dan sejuk, agar zat pewarna tdk lekas
luntur.
Tahan asam, gram positif dan gram negatif
• Ada
kalanya, setelah suatu sediaan yang sudah menyerap zat pewarna tertentu,
kemudian dicuci dengan asam encer, maka seluruh zat pewarna terhapus. Pewarnaan
gagal
• Ada
juga sediaan yg tahan terhadap asam encer, misal basil-ba-sil tbc dan
basil-basil berspora. Maka dikatakan, bakteri terse-but adalah bakteri
tahan asam, ini merupakan ciri khas spesies
• Ada
kalanya suatu sediaan perlu diwarnai 2 kali. Setelah zat pe-warna pertama
(ungu)terserap, maka sediaan dicuci dng alko-hol, kemudian ditumpangi dengan
zat pewarna yg berlainan, yaitu pewarna merah.
• Jika
kemudian sediaan ini dicuci dengan air lalu dengan alko-hol, maka 2 kemungkinan
bisa terjadi
• Pertama,
zat warna tambahan terhapus, sehingga yg tampak ia-lah zat pewarna asli (ungu).
Dalam hal ini sediaan (bakteri) dise-but gram positif.
Dinding sel gram positif dan gram negatif
• Gram
positip
• Mengandung
berlapis-lapis pep tidoglican
• Mengandung
asam teikhoat yg tersusun antara lain oleh glise rol dan fosfat
• Asam
teikhoat bermuatan nega tif, ada 2 tipe
• Asam
lipoteikhoat, merupakan transmembran yg berhubungan dengan membran
• Teikhoat
dinding sel yg berhu bungan dengan peptidoglikan
• Gram
negatip
• Memiliki
1-2 lapis peptido glikan
• Memiliki
membran luar
• Peptidoglikan
berhubungan de ngan lipoprotein pada membran luar
• Membran
luar mengandung;
• Lipopolisakarida
• Lipoprotein
• Fosfolipid
Konsep pewarnaan gram
• Sediaan
diwarnai gentian violet 3 menit (ungu)
• Direndam
lugol 45 detik
• Dicuci
dng alkohol 95% sampai tidak ada yang luntur
• Cuci
dengan air mengalir
• Warnai
dengan fuchsin (merah) 3 menit
• Cuci
dengan air mengalir
• Keringkan
diantara 2 kertas saring
• Amati
dengan mikroskop
• Sediaan
berwarna ungu → gram positip
• Sediaan
berwarna merah→gram negatif
• Untuk
gram positif warna gentian violet tidak
terlarut oleh alko-hol 95%, pewarna ini terserap sungguh-sungguh pada dinding
sel
• Untuk
gran negatif, dinding selnya tidak
menyerap warna gentian violet
• Penemu
pewarnaan ini christian gram
• Kemungkinan
ke-2, zat warna tambahan (merah) bertahan, hingga zat warna asli tidak nampak.
Dalam hal ini sediaan (bakteri) disebut gram negatif.
• Ada
pula bakteri yg pada usia tertentu berubah dari gram positif menjadi gram
negatif atau sebaliknya. Bakteri yang demikian disebut gram variabel. Jumlah
bakteri gram variabel tidak
banyak.
• Bakteri
gram positif lebih peka terhadap fenol, penisilin dan resisten terhadap
streptomisin
• Ciri
yang khas ini dipergunakan dalam penggolongan bakteri.

trimss infonya sangat bermanfaat...
BalasHapus